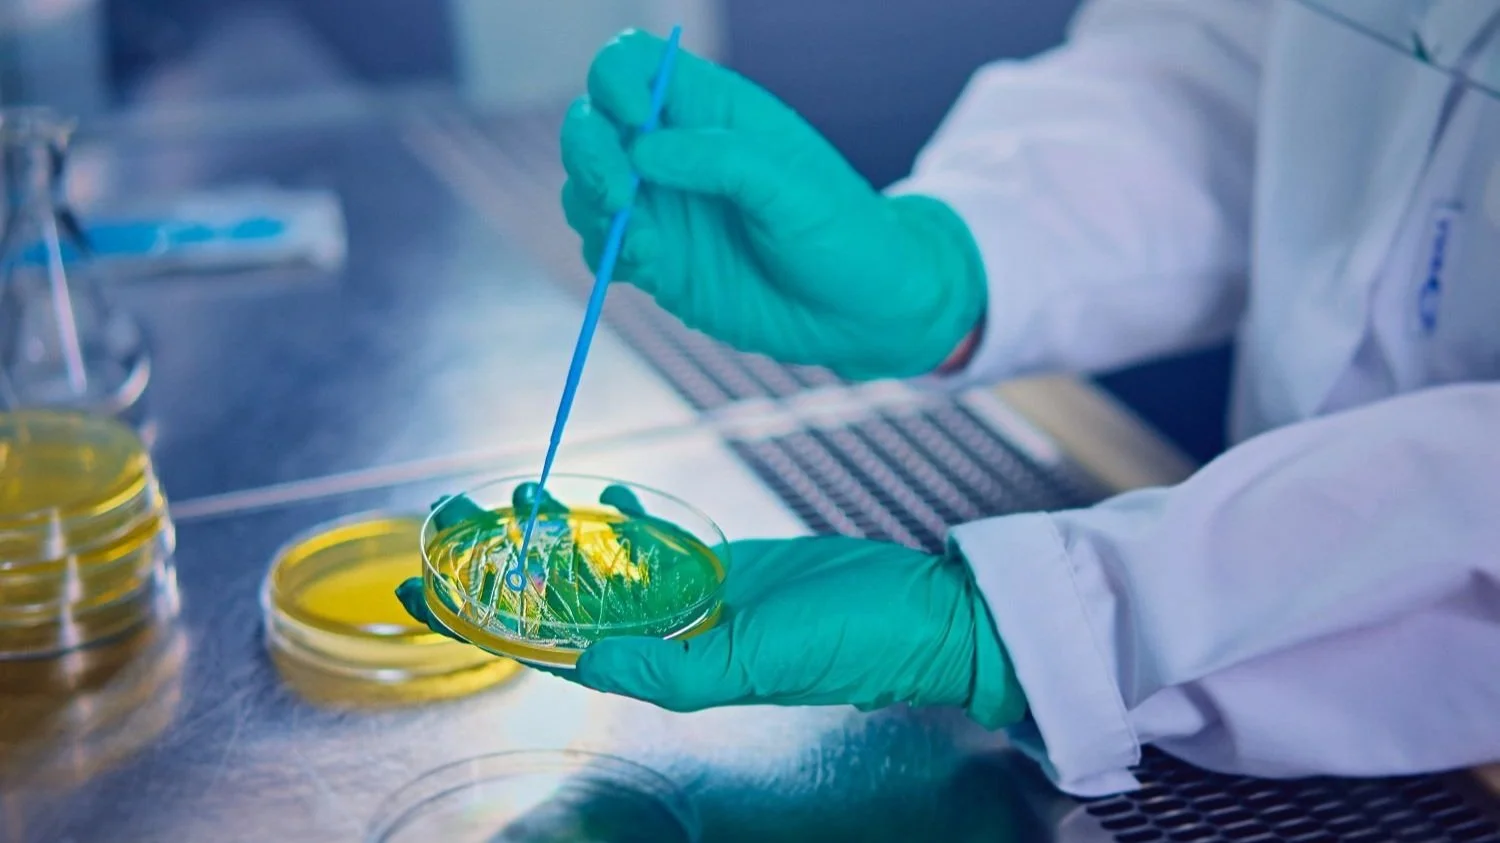

Business Finland's Research to Business (R2B) call is open!
The Spring 2025 Research to Business call is open, with the application deadline on March 5, 2025.
Business Finland will fund Research to Business projects in public research organizations where the project team prepares a research-based product or service idea for commercialization and carries out applied research which support the commercialization.
The Spring call includes several updates to take note of:
Business Finland can grant funding for 80% of total approved project costs.
In this call, Business Finland has not limited total costs of the funded project. Typical project costs are 300 000€ -700 000€ and we encourage to prepare projects of different sizes budgetwise.
Project ideas are not pitched to Business Finland before sending the application. This is a pilot for the spring round, as we have noticed that the preparation of project ideas is in very good shape.
Business Finland will organize an information session in January to go through these changes and revisit key points to support application preparation. Further details about the session will be shared later.